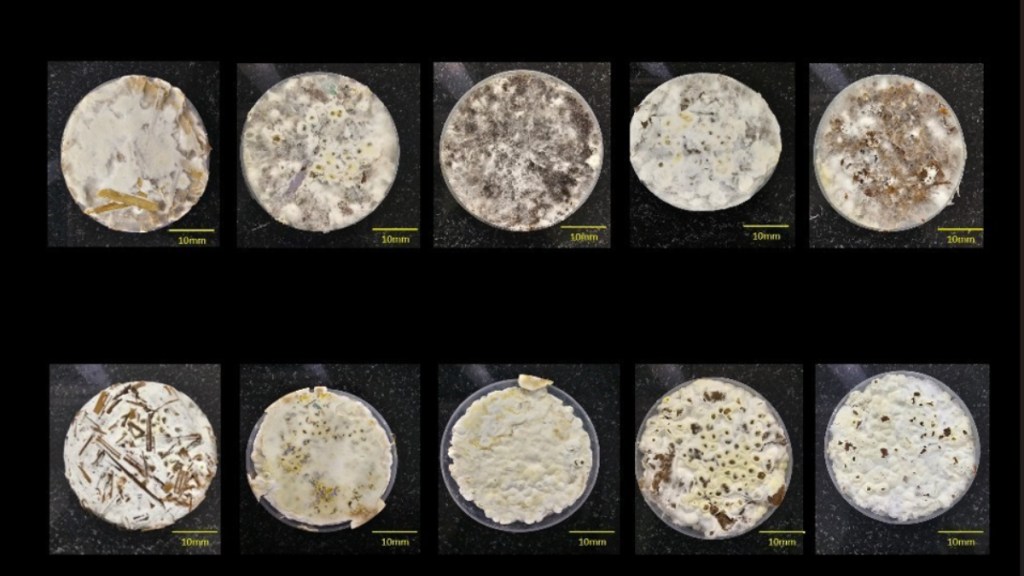

Lakshmana Venkat Kuchi
From Chennai researchers at IIT Madras comes a new packaging material made out of agricultural waste that can replace conventional plastic foams widely used in the packaging industry.
And what is more, the new material developed by the researchers has the potential to make a transformative impact on both the society and the environment through a practical solution to two major problems — plastic pollution and agricultural waste disposal — which can perhaps provide a solution to the burning of agricultural waste during winters that chokes the region and causes extreme pollution.
The Madras IIT researchers have demonstrated that mycelium-based biocomposites grown on agricultural and paper waste were found to provide quality in packaging while being biodegradable.
They managed to convert agricultural resides into high-strength biodegradable packaging materials, which can reduce plastic waste generated in the country, which according to credible estimates exceeds4 million tonnes annual, and and leverages the 350 million tonnes of agricultural waste generated each year.
These findings were published during June 2025 in the reputed, peer-reviewed journal Biosource Technology Reports, in a report co-authored by Research Scholars Ms. Sandra Rose Biby and Mr. Vivek Surendran and Dr. Lakshminath Kundanati from IIT Madras.
The researchers have already established a start-up, NatureWrks Technologies, co-founded by the lead researcher, Dr Lakshminathg Kundanti, a faculty at IIT Madras to develop commercialise innovative products by pursuing technology transfer in collaboration with industry partners.
According to a media statement issued by the IIT Madras, the research was funded by the NFIG (New Faculty Initiation Grant) of IIT Madras and the Ministry of Education, Delhi.
Explaining the significance of the research, Dr. Lakshminath Kundanati, Assistant Professor, Department of Applied Mechanics and Biomedical Engineering, IIT Madras, said, “In India, over 350 million tons of agricultural waste are generated annually, much of which is burned or left to decay, causing air pollution and wasting valuable resources. Our Research aimed to address both challenges—plastic pollution and agricultural waste—by developing mycelium-based biocomposites as sustainable, biodegradable packaging materials.”
Dr. Kundanati added, “This could certainly help address the issue of crop residue burning.”
At present, the research has demonstrated feasibility at the laboratory scale, with mechanical properties, water resistance, and biodegradability. The way forward includes optimizing substrate compositions for scalability, extending shelf life through natural coatings. By bringing this solution to market, the research aims to create affordable, eco-friendly packaging options that can replace harmful plastics, benefiting society through improved environmental health and economic opportunities. These composites can further be modified to cater to other engineering applications such as thermal and acoustic insulation materials.
Replacing plastic foams like EPS and EPE with mycelium-based biocomposites can significantly reduce landfill burden, prevent microplastic formation, and cut greenhouse gas emissions associated with plastic production and waste incineration, the researchers said. This technology also has potential to development in rural India by creating demand for agricultural by-products, potentially generating new income streams for farmers and rural communities.











